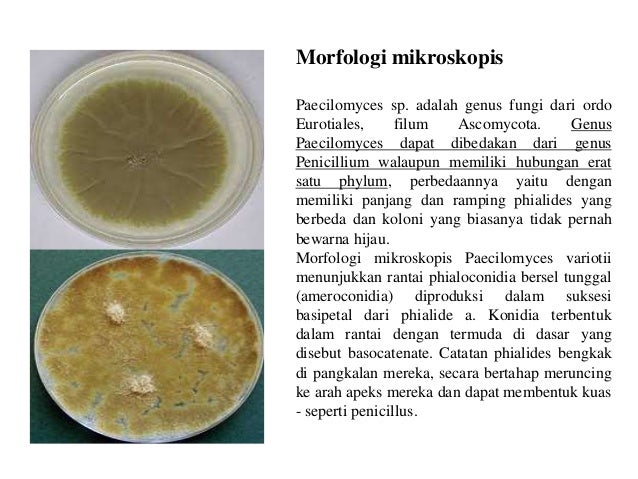

Info Baru 18 Jamur Parasit
Mei 30, 2021
Jamur parasit pada manusia, Jamur saprofit, Jamur parasit pada tumbuhan, Gambar jamur parasit, Jamur simbiosis mutualisme, Ciri ciri jamur parasit, Jamur yang bersifat parasit, Contoh jamur parasit fakultatif, Klasifikasi jamur, Jamur parasit obligat,
Info Baru 18 Jamur Parasit - Para desainer rumah terutama bagian gambar rak memiliki tantangan tersendiri dalam menciptakan rancangan atau desain bentuk gambar rak. Saat ini banyak model-model baru yang dicari oleh desainer Jamur Parasit efektif secara komposisi maupun bentuknya. Faktor tinggi peminat rumah nyaman dan indah, menjadi inspirasi para desainer gambar rak untuk menghasilkan kreasi yang baik.
Maka kami akan mengulas tentang gambar rak yang memiliki desain dan model kekinian, sehingga memudahkan anda membuat rancangan desain, dekorasi dan model yang nyaman.Berikut yang kami sampaikan tentang gambar rak dengan judul Info Baru 18 Jamur Parasit.

Live Biologi JAMUR BASIDIOMYCOTINA . Sumber Gambar : livebiologi.blogspot.com

Syarat Tumbuh Tanaman Jamur Tiram Ilmu Pertanian . Sumber Gambar : agrotek.id

Jamur Deuteromycota Contoh Gambar Jamur Deuteromycota . Sumber Gambar : www.biomagz.com

Latihan Soal Pengantar Mikrobiologi Topik Fungi Jamur . Sumber Gambar : wanenoor.blogspot.com
Penicillium Paecilomyces Aspergillus . Sumber Gambar : www.slideshare.net
PPT PROTISTA MENYERUPAI JAMUR PowerPoint Presentation . Sumber Gambar : www.slideserve.com

Gangguan pada Sistem Pernapasan Manusia dan Upaya untuk . Sumber Gambar : www.bukusekolah.net
Perbedaan Parasitisme dan mutualisme Usaha321 net . Sumber Gambar : usaha321.net

Cara Meningkatkan Sistem Imun Tubuh AKG FKM UI . Sumber Gambar : akg.fkm.ui.ac.id

BIOLOGI ITU SERU GANGGUAN KELAINAN PADA KULIT . Sumber Gambar : biologiituseru.blogspot.com

kehidupanalamsemesta Fungi Jamur . Sumber Gambar : kehidupanalamsemesta.blogspot.com